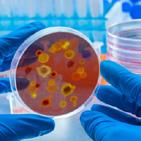

![]()






We are delighted to present our range of Care products.
At Comax, we know how much our customers in the care sector value competitive buying and a professional, reliable service. We work hard to bring you the very best products at the very best prices. Our range of care products have been carefully selected to suit the care environment and include everything you’ll ever need for cleaning all around your care home, surgery or hospital. The aim is to keep things simple, by using just a few well selected and highly effective cleaning essentials, you can ensure that:
• You don’t waste money buying and storing unnecessary cleaning products.
• The chemicals you have work well together rather than conflicting with each other and causing a hazard to health.
• By following our free dosing charts, you don’t use more chemical than you need.
•Through our COSHH Awareness courses, your cleaning staff will fully understand where and how to us the products.
• You can work towards your sustainability goals.
We can support your staff by providing specialised training courses, including COSHH Awareness for cleaning and catering staff, as well as advice on dealing with sickness and body spills, which can be particularly helpful for housekeepers.
We are confident that you’ll love our competitive pricing and prompt, fuss-free service. If you can’t find what you’re looking for in this brochure just give us call, our experienced team will be delighted to help.

Greg Prowse
Managing Director Comax UK

Phone: 01202 684111
Phone lines are open 8 am to 5.30pm, Monday to Friday
Email: sales@comaxuk.com | Web: www.comaxuk.com
Post: Comax UK, 2 Yeoman Road, Ringwood, Hampshire, BH24 3FA



®







OdorBac Tec4
Odour eliminator, stain remover and multipurpose cleaner with a fresh linen fragrance


Orange Citrus Degreaser Conc.
A highly versatile & powerful citrus cleaner concentrate


Glass & Interior Cleaner Conc.
Cleans interior surfaces, windows,


Acid Washroom & Limescale Cleaner
4-in-1 multi-action cleaner, disinfectant, descaler & deodouriser

4-Way Toilet
Descaler
Multi-action cleaner and limescale remover for most washroom surfaces and toilets


Carpet Extraction Cleaner Cherry
Highly perfumed shampoo & spot cleaner for carpets & upholstery

Stain & Odour Eliminator
approach to odour control








Katrin Liquid Hand Soap
Gentle on skin, and is certified sustainable and dermatologically tested


Katrin Santising Foam Handwash
Delivers mild, effective cleansing with rich, stable foam, dermatologically approved
Foam Handwashing Manual Dispenser Sanitary sealed foam soap slim dispenser

Coconut Luxury Hand & Body Wash Moisturises and cleanses when applied to damp skin.
We are here to help you care


CleanWorks



CleanWorks Microfibre Cloth is an economical yet versatile, absorbent blue cloth suitable for general use on hard surfaces and can be machine washed and reused.

The Microspeedy kit is a professional complete flat mopping system, which enables easier, faster and more effective cleaning.

Microspeedy Flat Cotton Looped Mop Head
Reusable up to 500 washes.Regular looped cotton mop - longer lasting for everyday mopping.

Microspeedy Microfibre Scrub Mop A tougher microfibre flat mop with scrub stripes for more abrasive cleaning of hard and safety floors.


Ultra-One Multi-Purpose Sanitising Wipes
Highly versatile multi-surface moist wipe for sanitsing all washable nonporous surfaces








Little Heroes
Sensitive Baby Wipes
66 wipes per pack,12 packs per case, 99% pure water, Made with skin loving natural fibres and recognised by the Birtish Skin Foundation.

iD Expert Cleansing
Patient Wet Wipes
Pack of 63 wipes
Chamomile - Prevents and calms skin irritations, Paraben Free, Alcohol Free, Dermatologically Tested - Proven to not cause skin irritations

Nilaqua Aerosol Free Skin Cleansing Foam 500ml
A gentle cleanser providing essential daily care with dignity. Delicate light soap fragrance; the “towel off” foaming, body wash & incontinence cleaner, effectively cleans skin & perineal area’s.

Lite Standard CONTI Wipes
Conti® lite combines strength and performance in a lightweight material. This everyday wipe provides a cost-effective, reliable option, for a range of care tasks.



Patient Cleansing Wet Wipes Bucket
Cotton enriched blend for added strength and softness. Delicate on the skin, and contains Aloe Vera. Effective against E-coli, Listeria, Salmonella and MSRA
Nilaqua Aerosol Free Skin Cleansing Foam 500ml
The world’s first 100% Biodegradable shampoo cap! Using patented technology this amazing shampoo cap has been designed to eradicate single use plastic and provide a deep clean to those in need - without water!
We are here to help you care


Blackcurrant Glycerin Swabsticks
Pleasant tasting and sugar-free, these lemon glycerin and blackcurrant glycerin oral swabsticks.

Abena Disposable Bib

Bioxtra Dry Mouth OralGel
Provides immediate relief of dry mouth as it supplementing the mechanisms present in natural saliva.

Napkin Style Dignified Clothing Protector
Adult Disposable Clothes
iD Expert Slip
All-In-One PE Plus

The iD Expert Slip is a range of all in one briefs for users to manage moderate to heavy urinary and faecal Incontinence.

TENA FIX PREMIUM
The reusable and breathable fixation pants have a seamless design that minimise pressure points.

iD Pants Pull Up Plus
The iD Pants are pull up briefs designed to allow users to maintain their independence and enjoy life to the full.

iD Expert Protect Bed Plus
Designed to provide a high level of protection, these bed and seat pads are made of an ultra–soft fluff, a polyethylene back sheet and soft non–woven sheet.

iD Expert Form Pad Plus
iD Expert Form are anatomically -shaped pads offering an ideal solution for managing moderate to heavy incontinence on mobile or semi-mobile patients.

iD Expert Protect Bed Super
Designed to provide a high level of protection and softness, our bed and seat pads are made of fluff, a polyethylene back sheet and soft non-woven sheet.
Protector with Adhesive Fastening and Reversible Pocket.
Adult Disposable Clothes Protector with Adhesive Fastening and Reversible Pocket.




Bedpan Liner Grey
Bed pan liner made of recycled and disposable pulp material with added waterproofing, manufactured in accordance with Medical Devices Directives 93/42/EEC

Commode Pan Liner Grey
The pulp general purpose bowl is a disposable pulp product medium bowl that is ideal for handling larger volumes of liquid.





OdorBac Tec4


Odour eliminator, stain remover and multipurpose cleaner with a fresh linen fragrance Orange Citrus Degreaser Conc. A highly versatile & powerful all-in-one citrus




Glass & Interior Cleaner Conc.
Cleans interior surfaces, windows, mirrors & plastic surfaces





Stain & Odour Eliminator
formula
approach to odour control and stain removal

Uniseal Floor Polish
Extra high solids, dry-bright metallised


Conforms to EN16777
Ultra Disinfectant
High performance cleaner disinfectant with broadspectrum activity against bacteria, yeast and viruses


re:mind Hand & Body
Wash
Premium quality product with mood-enhancing sweet orange and rosemary essential oils







Ultra-One Multi-Purpose Sanitising Wipes
Highly versatile multi-surface moist wipe for sanitsing all washable non-porous surfaces






re:mind Hand & Body Lotion
Mood-enhancing essential oils to revitalise and shea butter naturally containing nourishing antioxidants
re:mind Single & Double Wall Bracket
100% stainless steel lockable Brackets to hold 500ml RE:MIND Forever Glass Bottles.
Katrin Santising Foam Handwash



glass & mirror cleaning
CleanWorks Compostable Cleaning Cloth Colour-coded cloth


Delivers mild, effective cleansing with rich,stable foam,dermatologically approved. CleanWorks Microfibre Glass Cloth






Concentrated Washing Up Liquid
General purpose detergent for cleaning pots, pans, crockery and kitchen utensils

Catering Descaler
A heavy duty acid cleaning agent for the removal of hard water limescale
Hand hygiene






Cleaner & Sanitiser
Concentrate
Dual-purpose odourless detergent disinfectant, suitable for use in food preparation areas



Heavy Duty Degreaser Concentrate
powerful, fragrance-free

Destain & Tannin Remover
Liquid destainer that works as a pre-soak treatment to remove tannin stains from all types of crockery, cups and


Rinse Aid
rinse additive
A high-performance commercial dishwash detergent
the drying process in commercial dishwashers


Cleaning tools & paper consumables





5-in-1 Dishwash Capsules
All-in-one dishwasher capsule
dried-on grease for sparkly clean dishes










Acid Washroom & Limescale Cleaner
4-in-1 multi-action cleaner, disinfectant, descaler, and deodouriser T8

Heavy Duty Drain Unblocker
Removes heavy organic residues from bathroom pipes, drains and U-bends

4-Way Toilet Descaler
Heavy duty multi-action cleaner and limescale remover for all toilets

Bio Washroom Cleaner and Odour Eliminator
Eradicates organic soiling and helps maintain an odour-free washroom area

Pristine Air Freshener Solid 60 Day Refill
Comes in Citrus Mango, Linen Breeze & Bergamot & Sandalwood.

Pristine Solid Gel Air Freshener Citrus Burst
2-in-1 action, neutralises odours and fragrances the air, citrus burst fragrance.


Conforms to EN16777
Ultra Disinfectant
High performance cleaner disinfectant with broadspectrum activity against bacteria, yeast and viruses

Synthetic rubber powder-free glove


Disposable Apron
Flat packed LDPE
apron available in red, white and blue

Biohazard Body
Fluid Clean-Up Kit
Single application pack

CleanWorks Compostable Cleaning Cloth
Colour-coded cloth

Tork Antimicrobial Foam Soap
Combines hand washing and sanitizing, effective against bacteria and viruses, and reduces cross-contamination.


Tork Mild Foam Soap
Tork Mild Mini Liquid Soap has moisturising and replenishing ingredients proven mild to the skin for gentle hand washing.
Tork Liquid and Spray Soap Dispenser
Tork skin care dispensers, with armlever option, ensure hygiene in demanding environments, featuring easy refilling and Easy to Use certification.




Microfibre Cloths
and



Eco Luxury Soft Toilet Tissue
Luxury 2Ply recyeled toilet tissue, 250 sheet

Laundry Emulsifier




Powerful cleaning in all temperatures and will give improved wash results and helps remove heavy greasy and oily stain on all fabric. Laundry Destaining Powder

Non-Bio & Bio Washing Capsules

Laundry sorting


Laundry


Drawstring

We are here to help you care
Care and Nursing Homes on-premise laundry faces many challenges, from to increased hygiene requirements
provide the next generation in commercial
cost savings to Care Homes
Washing at low temperatures is proven to Super premium laundry solution minimises
disinfection
Cleanline Super Laundry Hygiene Detergent has been extensively tested under strict against harmful bacteria strains including
Achieving great cleaning reduces re-washes and save costs
We supply and install all dosing equipment to your washing machine





We are here to help you care


OdorBac Tec4
Odour eliminator, stain remover and multipurpose cleaner with a fresh linen fragrance


Orange Citrus Degreaser Conc
A highly versatile & powerful all-in-one citrus cleaner
T5


Glass & Interior Cleaner Conc

Stain & Odour Eliminator
Cleans interior surfaces, windows, mirrors & plastic surfaces
T4
Infection control


Conforms to EN16777
Ultra Disinfectant
High performance cleaner disinfectant with broadspectrum activity against bacteria, yeast and viruses
a long-term approach to odour control
hygiene




CleanWorks Microfibre Cloths
CleanWorks Microfibre Cloth is an economical yet versatile, absorbent blue cloth suitable for general use on hard surfaces and can be machine washed and reused.

CleanWorks Compostable

Yellow Clinical Waste Sack



Ultra-One Multi-Purpose Sanitising Wipe
Highly versatile multi-surface moist wipe for cleaning and disinfecting all washable non-porous surfaces
and spill control

Nitrile Glove



Disposable Apron
Flat packed LDPE
apron available in red,

Katrin Liquid Hand Soap
Gentle on skin, and is certified sustainable and dermatologically tested.




Katrin Santising Foam Handwash
Delivers mild, effective cleansing with rich, stable foam, dermatologically approved
Foam Handwashing Manual Dispenser
Sanitary sealed foam soap slim dispenser


Tork Mild Foam Soap
Tork Mild Mini Liquid Soap has moisturising and replenishing ingredients proven mild to the skin for gentle hand washing
Tork Antimicrobial Foam Soap
Combines hand washing and sanitizing, effective against bacteria and viruses, and reduces cross-contamination.
Cleaning Cloth
Colour-coded cloth.

The pulp general purpose bowl is a disposable pulp product medium bowl that is ideal for handling larger volumes of liquid.
clinical waste refuse sack

Bins
Sharps bins allow you to safely dispose of sharp objects that can pose a serious risk to your health through an infection.



Hygiene Couch Rolls
Protect your patient couch with a hygiene roll and maintain a high level of hygiene.
•











